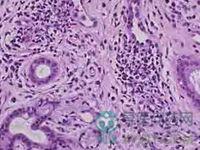

厥脱是由各种致病因素急剧影响,导致人体阴阳平衡失调、气血逆乱、阳气衰亡、阴血外脱的危重病证。临床以面色苍白、四肢厥冷、大汗淋漓、表情淡漠或烦躁不安、脉细弱、血压急剧下降为主要特征。
就诊科室:中医科 中医综合易感人群:无特殊人群需做检查:尿常规 血浆渗透压(POP) 血常规 便常规常用药物:参麦注射液 醋酸可的松片 注射用甲泼尼龙琥珀酸钠 右旋糖酐40葡萄糖注射液 右旋糖酐40氯化钠注射液 氢化可的松片 辅酶Q10氯化钠注射液 右旋糖酐70葡萄糖注射液 右旋糖酐20葡萄糖注射液 人血白蛋白 氢化泼尼松注射液 羟乙基淀粉40氯化钠注射液 呋塞米片 注射用呋塞米 呋噻米注射液 盐酸多巴胺注射液 硫酸阿托品注射液典型症状:表情淡漠 烦躁不安 冷汗淋漓 面色苍白 弱脉 少尿 四肢发冷 无尿 血压下降传染方式:无传染性治疗方式:无传染性相关疾病:产后虚脱 肝厥 煎厥 厥证 色厥色脱 尸厥 痰厥 脱阳